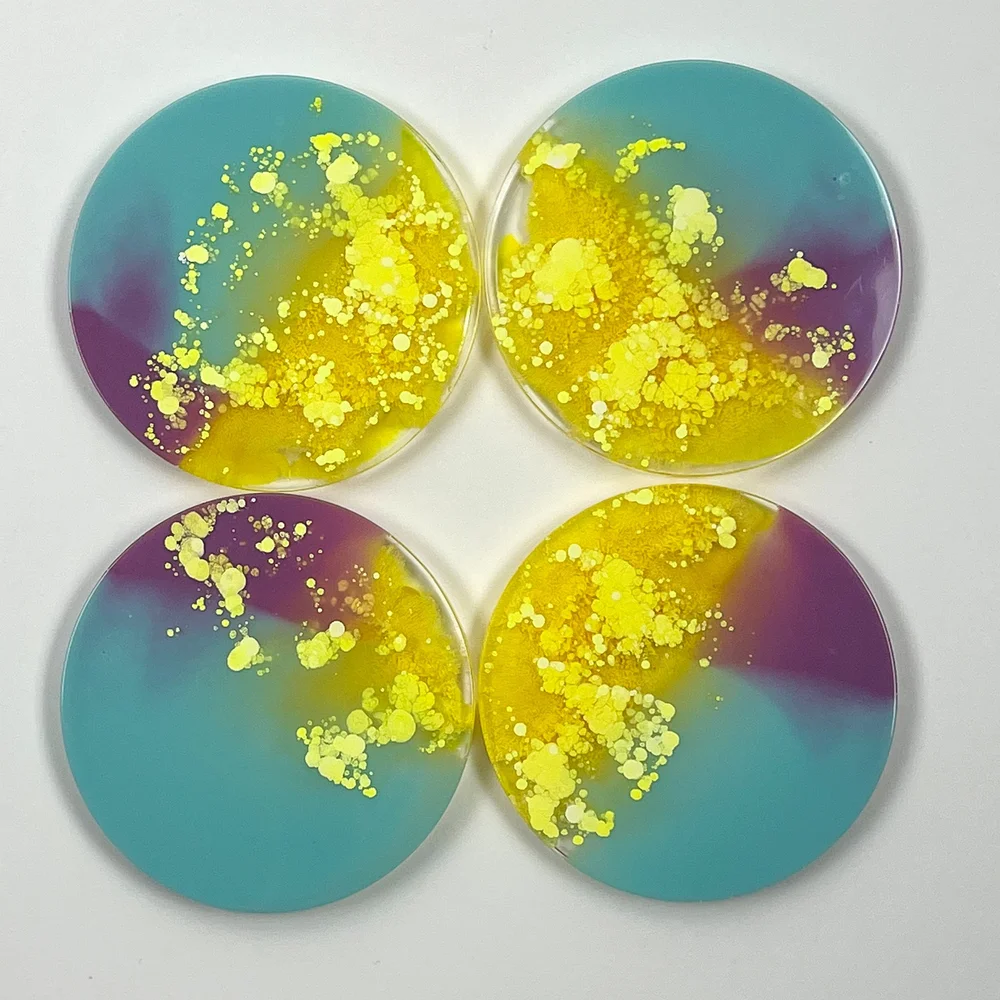

マイストア
変更
お店で受け取る
(送料無料)
配送する
納期目安:
2025.09.27 14:26頃のお届け予定です。
決済方法が、クレジット、代金引換の場合に限ります。その他の決済方法の場合はこちらをご確認ください。
※土・日・祝日の注文の場合や在庫状況によって、商品のお届けにお時間をいただく場合がございます。
cheeseオーダーページ Cheez-It Snapd Double Cheddar, 20 oz. | BJ's Wholesale Clubの詳細情報
Cheez-It Snapd Double Cheddar, 20 oz. | BJ's Wholesale Club。Cheez-It Puff'd Double Cheese 3 oz Inner Pack: 6 - 252962。Cheez-It Whole Grain Cracker Atomic Cheddar - 0.75 oz。いつもご愛顧頂き誠にありがとうございます(^^)◆エメラルドリングお直し(2段に変更)【4000円】◆ダイヤPt900リング【16000円】◆パープルサファイアPt900リング【18000円】◆ミントトルマリンPt900リング【18000円】以上4点、合計額:【52000円】リピーター様割引、おまとめ割引致しますm(__)m※発送方法は佐川急便/日本郵便(宅急便コンパクト)での発送を予定しております。お手持ちのモニター環境によってお色味が違って見える場合がございます。※天然石の為表面に傷やクラックがある場合がございます。ご了承下さい。ZZ TOP - Afterburner - CD Album - near mint - 1985 | eBay。※自然光下で撮影しております。桃叶 幸せのバトンタッチ。[Tak@Kashiwa様のルーム] モルガンダラー コインリング アクセサリー。※1点1点丁寧に作った物ですが手作業でお石等を止めたりアームを作成している為傷や歪みなどある場合がございます。Komugi カレンシルバー ハンドメイド エスニック #62 #4セット。ラベンダーヒスイリング。※細心の注意を払いお作り致しますがお預かりしたルースが万が一破損する場合がございます。マダラニンゲン目玉リングDIR EN GREY sukekiyo。希少なシラー入りです!!★ブラジルアレキサンドライト★オーダー受付中。素敵なご縁を心より楽しみにしております⭐
ベストセラーランキングです
近くの売り場の商品
カスタマーレビュー
オススメ度 4.4点
現在、2304件のレビューが投稿されています。